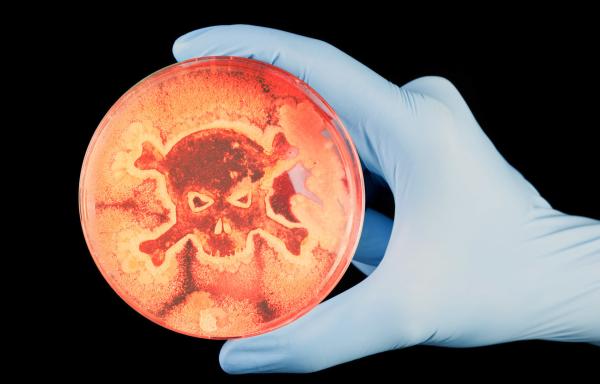
Bild 1 von 1: Bakterien gelten als Evolutionswunder. Wenn multiresistente Keime ihre Widerstandsfähigkeit untereinander weitergeben, wird das zum Problem.

42 - Die Antwort auf fast alles
Kommt die Superkeim-Pandemie? (2025)
Bakterien gelten als Evolutionswunder. Wenn multiresistente Keime ihre Widerstandsfähigkeit untereinander weitergeben, wird das zum Problem.
Bildauswahl:

Bakterien gelten als Evolutionswunder. Wenn multiresistente Keime ihre Widerstandsfähigkeit untereinander weitergeben, wird das zum Problem.
Themen
Hinweis
Top-Spielfilm am 16.03.
artearte
20:15
In einer französischen Kleinstadt führen Lucienne und Pierre eine geheime Liebesbeziehung. Um diese ungestört ausleben zu können, ermorden sie ihre Ehepartner. Aber als Konsequenz ihrer Tat wird es ihnen erst recht unmöglich, sich zu treffen. Claude Chabrol geht in „Blutige Hochzeit“ (1970) der Frage nach, weshalb Menschen lieber einen Mord begehen, als zu ihren Gefühlen zu stehen.In...
Blutige Hochzeit
Blutige Hochzeit
21:45
00:05
22:45
TVinfo
X